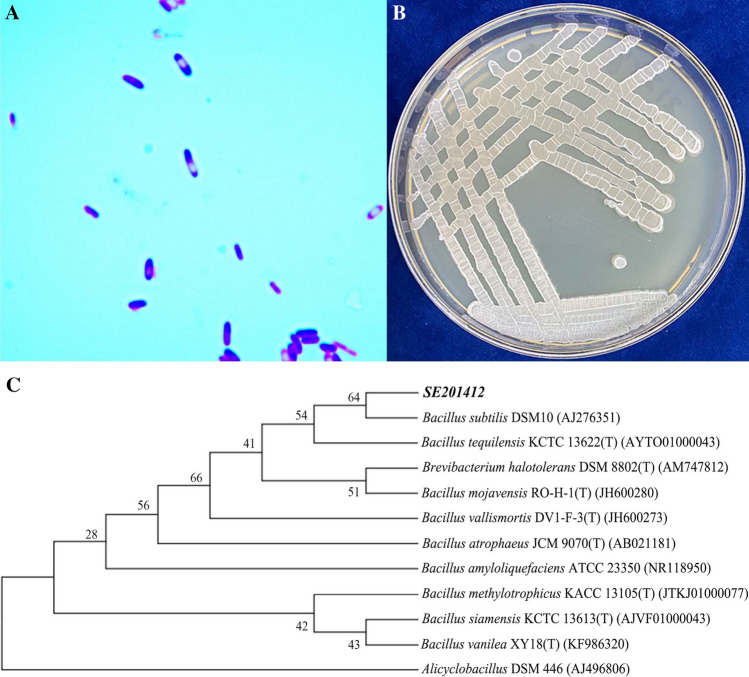
Figure 1

Abstract
In order to improve the functionality and additional value of agricultural products, this study developing nano-selenium fermentation broth and established a new application strategy of bio-nano-selenium by screening and identifying selenium-rich microorganisms. We isolated a new strain from tobacco waste and named it Bacillus subtilis SE201412 (GenBank accession no. OP854680), which could aerobically grow under the condition of 66,000 mg L−1 selenite concentration, and could convert 99.19% of selenite into biological nano-selenium (BioSeNPs) within 18 h. Using strain SE201412, we industrially produced the different concentrations of fermentation broth containing 5000–3000 mg L−1 pure selenium for commercial use. The synthesized selenium nanoparticles (SeNPs) were characterized by scanning electron microscopy (SEM), transmission electron microscopy (TEM), and nanoparticle tracking analysis (NTA). TEM and SEM results showed that SeNPs were distributed outside cells. NTA assay of fermentation broth indicated that the nanoparticles were spherical with an average particle size of 126 ± 0.5 nm. Toxicity test revealed that the median lethal dose (LD50) of the fermentation broth to mice was 2710 mg kg−1, indicating its low toxicity and high safety. In addition, we applied BioSeNP fermentation broth to rice and wheat through field experiments. The results showed that the application of fermentation broth significantly increased the total selenium content and organic selenium percentage in rice and wheat grains. Our findings provide valuable reference for the development of BioSeNPs with extensive application prospects.
Subject terms: Biotechnology, Plant sciences
Introduction
Selenium is an essential trace element that plays an important role in the human health, especially in the fight against cancer1. Compared with inorganic and organic selenium, nano selenium with high particle dispersion, high bioactivity, low toxicity, and high human tolerability have attract extensive attention due to their broad application prospects2. Selenium nanoparticles (SeNPs) absorbed by the human body play a role in many physiological processes such as growth, reproduction, and immune regulation3, and they can protect the human body from the toxic effects of heavy metals and chemicals by reducing the production of reactive oxygen species (ROS)4,5. There are three main methods for the synthesis of SeNPs, namely, physical, chemical, and biological methods6. Compared with other methods, the biological method is more effective since the nano-selenium synthesized by biological method is more stable7,8. In biological synthesis process, biomolecules cover the surface of nano-selenium, thus blocking its aggregation and increasing its stability, and therefore biosynthesis method has become a new trend in the preparation of SeNPs9.
Currently, many plant extracts have been applied to preparing SeNPs. Song et al.10 prepared SeNPs with the particle size range of 50–150 nm through reaction of ascorbic acid (AA) and sodium selenite (Na2SeO3) using konjac glucomannan (KGM) as a stabilizer. Zhang et al.11 used Lycium barbarum polysaccharide (LBP) and Lycium barbarum protein conjugate (LBPP) respectively as stabilizer and dispersant to maintain the particle size of LBPP1-SeNPs within the range of 111.5–117 nm. Yilmaz et al.12 synthesized spherical SeNPs with the particle size range of 20–50 nm through the reaction of tarragon extract and sodium selenite. The results showed that the SeNPs synthesized from plant extracts were small in particle size, stable, non-cytotoxic, and environmentally friendly13.
Microbial green synthesis of selenium nanoparticles is currently a hot topic in the field of biosynthesis of selenium nanoparticles. Afzal et al.14 synthesized orange-red biogenic selenium nanoparticles (BioSeNPs) with a spherical shape and a particle size of 10.8 nm using cyanobacteria. El-Saadony et al.15 biosynthesized SeNPs with an average particle size of 56.91 ± 1.8 nm from lactic acid bacteria (LAB) isolated from human milk. Li et al.16 used the plant inter-rhizosphere-promoting bacterium Rahnella aquatilis HX2 to reduce selenite into BioSeNPs, and found that both FliC and OmpF proteins could control the assembly and stability of BioSeNPs. Sun et al.17 synthesized spherical SeNPs with a diameter of approximately 48 nm from selenium-rich strain 2322 Rhodobacter erythropolis through fermentation. Huang et al.18 isolated and identified a highly selenite-resistant (800 mM) strain Providencia rettgeri HF16 from coal mine soil, and based on this strain, they synthesized SeNPs with the particle size range of 120–295 nm. Tugarova et al.19 prepared SeNPs with the size range of 25–80 nm from strains Sp7 and Sp245 Azospirillum brasilense. Lian et al.20 prepared SeNPs with the particle size range of 70–90 nm from cell-free extracts of a novel yeast Magnusiomyces ingens LH-F1. Sara and Mohammad21 tested the ability of Enterococcus faecalis to transform sodium selenite into SeNPs, found that the transformed spherical BioSeNPs had a particle size ranging from 29 to 195 nm. All these studies prepare nano-selenium based on the transformation of selenium salts by microorganisms such as bacteria, fungi, and actinomyces. This microorganism synthesis method has mild reaction conditions, high stability, and environmental friendliness, and thus more suitable microbial species remain to be explored for the synthesis of SeNPs.
Although, there are many reports on the SeNP synthesis, most of them focus on the characterization and potential applications of SeNPs, and few reports on factory production and application of SeNPs are available. Therefore, in this study, a strain with high SeNP transformation efficiency and high sodium selenite tolerance was isolated from tobacco waste and characterized, and its factory-produced fermentation broth was subjected to toxicological tests and particle size analysis, and our developed nano-selenium fermentation broth was applied to rice and wheat, exhibiting high absorption, transport, and bioavailability.
Materials and methods
Strains and growth conditions
This strain was isolated from fermented tobacco waste from Enshi Tobacco Reroasting Plant in Hubei province in the early stage, named SE201412, and stored in China Typical Culture Preservation Center (Wuhan, China) with a storage number of CCTCC NO.ZM2015708. The 1 g tobacco sample was placed in a triangular bottle filled with 99 mL sterile water and shaken thoroughly. The solution was gradiently diluted 10−2–10−8 folds. The 0.1 mL diluted solution at different concentrations was plated evenly on LB medium. Each sample had 3 replicates. After being cultured at the constant temperature of 30 °C for 24 h, the 5 single colony strains with different morphologies were selected from the tobacco samples, and were transferred to the media on sterile plates for further culture. These five strains were cultured on LB medium added with different concentrations of sodium selenite (300–700 mg mL−1) for selenium resistance test. The strain with best growth state was selected, isolated, and purified using the streak plate method until no other bacteria appeared on the petri dishes.
LB solid medium was prepared by mixing 10 g L−1 sodium chloride, 10 g L−1 tryptone, 5 g L−1 yeast extract, 15 g L−1 agar powder and autoclaving at 121 °C for 20 min. Sodium selenite medium (500 mg L−1) was prepared by mixing 10 g L−1 sodium chloride, 10 g L−1 tryptone, 5 g L−1 yeast extract, 15 g L−1 agar powder and autoclaving at 121 °C for 20 min, followed by cooling to about 60 ℃ and the addition of 100 μL of prepared sodium selenite (500 mg mL−1) into every 100 mL LB solid medium to reach the final concentration of 500 mg L−1. Other concentrations of sodium selenite medium was prepared by adding corresponding volume of 500 mg mL−1 sodium selenite to LB solid medium.
Characterization of strain
Bacterial gram staining experiment and cell morphology observations were performed under 100× microscope. Bacterial species were identified by the 16S rRNA method, and the sequences obtained were submitted to the NCBI database for BLAST alignment. The evolutionary tree was constructed using the Neighbour-Joining method using MAGA 7.0. The physiological and biochemical identification of bacteria was performed according to the Berger's manual.
Localization of SeNPs in cells
To investigate the distribution characteristics of generated SeNPs in cells, bacterial cultures were analyzed by transmission electron microscopy and scanning electron microscopy. The bacteria in treatment groups were cultured in LB medium supplemented with 500 mg L−1 Na2SeO3, and those in the control group were cultured in LB medium with no Na2SeO3 supplementation.
Production of BioSeNPs fermentation broth
Purified strain SE201412 was selected from the sterile environment, cultured in the enlargement medium for 6–9 h at 30 °C and 150 r min−1, and transferred to the 200 L stainless steel self-controlled fermenter for fermentation (Fig. 1). LB medium was loaded into the fermenter to 70% of its volume and sterilized for 25 min under 0.12 MPa. When the medium temperature was lowered to 35 °C and bacterial growth reached the logarithmic growth phase (6 h), 10% sodium selenite was added, and at the end of the logarithmic growth phase, the remaining 90% sodium selenite was added. When sodium selenite was added, sterile air was introduced to keep the fermenter under positive pressure. The pressure and temperature of fermenter were set as 0.04–0.05 MPa and 30 ± 5 °C, respectively. In the fermenter, the pH value was 6.0, and the dissolved oxygen percentage was 60–100%. The speed of mixing was 190 r min−1. After fermentation for 18–24 h, 140 L fermentation broth was obtained.
Figure 1.
Characterization and identification of strain SE201412. (A) Morphology of strain SE201412 under optical microscope (×1000). (B) Culture of strain SE201412 in the medium without additional sodium selenite. (C) Phylogenetic tree of strain SE201412.
Conversion rate from inorganic selenium to organic selenium
The total and organic selenium in fermentation broth samples and mature grains of wheat and rice were determined by Enshi laboratory of Hubei Bureau of Geology and Mining. The selenium content was determined by atomic fluorescence spectrometry in ecogeochemical evaluation methods22. Oranic selenium conversion rate was calculated according to the following formula.
Toxicity test of BioSeNPs fermentation broth
The toxicity test (GB 15193.3-2014) of BioSeNP fermentation broth was performed in a barrier environment animal room with animal experiment license number of SYXK (Zhe) 2016-0012 at room temperature 20.6–23.0 °C and relative humidity 57.9–64.2%. The test animals were ICR mice including 20 male and 20 female mice, provided by Zhejiang Experimental Animal Center with mouse production license number of SCXK (Zhe) 2014-0001. The BioSeNP fermentation broth sample was diluted with pure water and orally gavaged to mice.
The oral gavage doses were set as 10,000 mg kg−1, 4640 mg kg−1, 2150 mg kg−1 , and 1000 mg kg−1 by Horn's method, and the animals were fasted for 4 h before poisoning. The animal autopsy was performed at 14 days after poisoning.
Characterization of particle size of SeNPs in fermentation broth
The particle size of SeNPs in fermentation broth prepared from strain SE201412 was measured by tracking Brownian motion trajectory using the NanoSight NS300 Nanoparticle Tracking Analyzer (NTA). The specific parameters of NTA assay were set as follows: NTA Version, NTA 3.4 Build 3.4.4; script used, SOP Standard Measurement 04-45-33PM 28O ~; camera type, sCMOS; laser type, Blue488; camera level, 9; slider shutter, 440; slider gain, 22; FPS, 25.0; number of frames, 1498; temperature, 23.9 ℃; viscosity, (Water) 0.912-0.912 cP; dilution factor, 1 × 10−3; syringe pump speed, 100; detection Threshold, 5; and max jump distance,17.0–20.0 pix (Auto).
Application of BioSeNP fermentation broth to rice
We conducted a field plot trial by foliar spraying of 30 mg L−1 bioSeNP fermentation broth at different dosages (0 mL h−2, 3000 mL h−2, 4500 mL h−2, 6000 mL h−2, 7500 mL h−2, and 9000 mL h−2) in the early stage of filling of two rice varieties (E Xiang 2 and E Zhong 5), respectively. The total and organic selenium contents in the refined rice grains was measured after harvest. The field management was consistent with the local rice field management pattern.
Application of BioSeNP fermentation broth to wheat
Twenty-four wheat varieties mainly promoted in the Yangtze River basin of China were selected for foliar spraying of 30 mg L−1 bioSeNP fermentation broth at the dose of 4500 mL hm−2 in the early filling stage. The experiments were performed in triplicates. After harvest, the total and organic selenium contents in the wheat grains were detected. The field management was consistent with the local wheat field management pattern.
Statistical analysis
Non-parametric Kruskal–Wallis H test and Duncan’s multi-range test in SPSS version 22.0 were performed to assess differences of selenium content in rice and wheat, respectively. Origin version 9 was used for plotting. P < 0.05 was considered as statistically significant.
Results and discussion
Identification of strain SE201412
We isolated a strain with high tolerance to sodium selenite and transformation efficiency from tobacco waste. The assays of morphological, physiological, and biochemical characteristics, electron microscope scanning, and 16S rRNA gene sequence analysis jointly indicated that this isolated strain was a new strain. This strain was named Bacillus subtilis SE201412, and its 16S rRNA sequence was submitted to the Genbank database with the registration number of OP854680. After gram staining, the color of SE201412 was observed to be purple (Fig. 1A), therefore this strain was positive. The colony was milk white and opaque with rough surface (Fig. 1B). The strain was stem-shaped with its endospore diameter of less than 1 µm (Fig. 2A). Moreover, bacterial body of this strain did not swell with lateral flagella, which conformed to the morphological characteristics of Bacillus (Fig. 2A). Phylogenetic and evolutionary analyses also showed that the SE201412 strain was closest to Bacillus subtilis DSM10 (AJ276351) (Fig. 1C). The 16S rRNA sequencing results indicated that the isolate strain SE201412 was similar to Bacillus tequilensis (AYTO01000043) and Bacillus subtilis subsp. Inaquosorum (AMXN01000021) with a 16S rRNA gene sequence similarity of 99.93% (Supplementary materials, Table S1). In addition, physiological and biochemical assays showed that strain SE201412 had the typical characteristics of Bacillus subtilis (Table 1). Therefore, isolate strain SE201412 was identified as Bacillus subtilis SE201412, and the 16S rRNA gene sequence obtained in this study was shown in Table S2, and the BLAST alignment results were shown in Table S1.
Figure 2.
Transmission electron microscope (TEM) observation of strain SE201412. (A,B) Strain SE201412 after 6-h culture in 500 mg mL−1 sodium selenite medium. (C) Strain SE201412 after 6-h culture in sodium selenite- free medium.
Table 1.
Physiological and biochemical characteristics of bacterial strain SE201412.
| Test item | Test result |
|---|---|
| Nitrate reduction into nitrite | + |
| Catalase | + |
| Hydrolyzed gelatin (protease) | + |
| Arabinose | + |
| Ribose | + |
| Fructose | + |
| Mannitol | + |
| Gram straining | + |
| Morphology of cell | Stem-formed |
| Flagellum | Lateral flagella |
| Mobility | Mobile |
| Alienation effect | Aerobic |
| Type of spore | Endospore |
+ means positive.
The Bacillus sp. capable of preparing SeNPs have been reported as Bacillus niabensis OAB223, Bacillus paramycoides SP324, Bacillus mycoides SeITE0125, Bacillus sp. MSh-126, Bacillus amyloliquefaciens SRB0427, etc. Bacillus subtilis is an aerobic bacterium widely distributed in soil and decaying organic matter, with fast growth rate, low nutritional requirements, efficient secretion of many proteins and metabolites, and no toxin production, which is a non-pathogenic and safe microorganism28. The strain SE201412 we identified for efficient preparation of selenium nanoparticles belonged to Bacillus subtilis of the genus Bacillus, which was not only corroborated that Bacillus has better tolerance and transformation effect on sodium selenite and is a good resource pool for screening efficient selenium-enriched bacteria, but also, illustrated that the strain SE201412 is a safe selenium-enriched microorganism.
Characterization of SeNPs
Since many bacteria have the ability to reduce sodium selenite to SeNPs, we investigated whether SE201412 strain could reduce selenite into Se0 to form SeNPs. TEM micrographs showed the presence of SeNPs produced by Bacillus subtilis SE201412 in bacterial cells and medium added with 500 mg L−1 sodium selenite (Fig. 2A), but no SeNPs were observed in SeNPs were not observed in the cells (Fig. 2B), while no SeNPs were observed in the medium added with no sodium selenite (Fig. 2C). After 6-h incubation in the medium containing 500 mg L−1 sodium selenite, SeNPs were distributed outside the cells. SEM micrographs clearly showed extracellular spherical SeNPs of different sizes (Fig. 3A), while no SeNPs were found in the selenium-free medium (Fig. 3B).
Figure 3.
Scanning electron microscopy (SEM) observation of strain SE201412. (A) Strain SE201412 after 6-h culture in 500 mg mL−1 sodium selenite medium. (B) Strain SE201412 after 6-h culture in sodium selenite- free medium.
It was shown that thioredoxin reductase (TrxR) in Bacillus uses NADPH as an electron donor to directly reduce selenite to nanoselenium29. Compared to intracellularly distributed nanoselenium, the extracellular distribution of nanoselenium after synthesis results in nanoselenium being mobile and the synthesized nanoselenium being immediately present in the environment, and the extracellular nanoselenium is more easily recovered28. Therefore, the distribution of microbial-derived nanoselenium outside the cell is advantageous. Bacillus subtilis SE201412 could secrete nano-selenium with typical red color outside the cell after 6 h of culture, which had a shorter transformation time and better transformation effect compared with the existing reported selenium-enriched microorganisms23–27, but its specific transformation mechanism is not clear and needs further study.
Particle size and toxicity of BioSeNP fermentation broth
Using strain SE201412, we produced the different concentrations of BioSeNP fermentation broth with pure selenium content of 5000 mg L−1, 10,000 mg L−1, 15,000 mg L−1, 20,000 mg L−1, 25,000 mg L−1 , and 30,000 mg L−1, respectively (Fig. 4), and the conversion rate from total selenium to organic selenium reached more than 99% (Table 2). The sodium selenite tolerance test found that the strain had high selenite tolerance and transformation ability, which could tolerate up to 66,000 mg L−1 (383 mM) sodium selenite and transform over 99% of sodium selenite into red SeNPs within 18 h. It has been reported that selenium tolerance of microorganisms generally ranges from 1 to 100 mM, and that of Rhodopseudomonas palustris N is 8 mM30. The selenium tolerance of Streptomyces sp. ES2-5 is 80 mM31, and the highest selenium tolerance of Proteus mirabilis YC801 is 100 mM32. However, the selenium tolerance capacity of the Bacillus subtilis SE201412 (383 mM) was much higher than that of these known bacteria. The SeNP synthesis capacity of different species of bacteria varies greatly since SeO32− and SeO42−, as a toxic substance, affect the growth or metabolism of bacteria to various degrees. Therefore, bacteria need to tolerate certain concentration of SeO32− or SeO42− first, and then use their own detoxification mechanism to synthesize SeNPs33. Relevant studies have indicated that up to 40% selenium tolerance genes or proteins have been detected in Bacillus, which was considered to be an excellent selenium tolerance bacteria and an excellent bacterial resource for SeNP biosynthesis34,35.
Figure 4.

BioSeNP fermentation broth at different concentrations produced by strain SE201412. (A) Pure selenium content of 5,000 mg L−1. (B) Pure selenium content of 10,000 mg L−1. (C) Pure selenium content of 15,000 mg L−1. (D) Pure selenium content of 20,000 mg L−1. (E) Pure selenium content of 25,000 mg L−1. (F) Pure selenium content of 30,000 mg L−1.
Table 2.
Selenium content in fermentation broth at different concentrations produced by strain SE201412.
| Typea | Total selenium content (mg L−1) | Organic selenium content (mg L−1) | Percentage of organic selenium (%) |
|---|---|---|---|
| A | 5017 | 4990 | 99.46 |
| B | 10,031 | 9962 | 99.31 |
| C | 14,989 | 14,914 | 99.50 |
| D | 20,004 | 19,898 | 99.47 |
| E | 25,053 | 24,960 | 99.63 |
| F | 30,068 | 29,824 | 99.19 |
a(A) A total of 11,000 mg sodium selenite was added in the average production of 1 L fermentation broth. (B) A total of 22,000 mg sodium selenite was added in the average production of 1 L fermentation broth. (C) A total of 33,000 mg sodium selenite was added in the average production of 1 L fermentation broth. (D) A total of 44,000 mg of sodium selenite was added for the production of 1 L fermentation broth. (E) A total of 55,000 mg of sodium selenite for the production of 1 L fermentation broth. (F) A total of 66,000 mg of sodium selenite for the production of 1 L fermentation broth.
The particle size of SeNPs in the fermentation broth (10,000 mg L−1) produced by strain SE201412 was also examined (Fig. 5). The NTA results showed that the average particle size of SeNPs in the fermentation broth was 126 ± 0.5 nm, that D10 (when particle size distribution reaching 10%) was 78.6 ± 0.3 nm, that D50 (reaching 50%) was 113.4 ± 2.6 nm, and that D90 (reaching 90 50%) was 188.0 ± 7.8 nm. Compared with inorganic and organic selenium, SeNPs has higher bioactivity and lower toxicity. SeNPs synthesized by microbial reduction method is stable with excellent biological activity. Wang et al.36 successfully synthesized SeNPs with a particle size of 50–400 nm in vitro using Bacillus subtilis. Dhanjal and Cameotra identified a Bacillus cereus strain that can reduce selenite to SeNPs with a diameter of 150–200 nm under aerobic conditions37. Our NTA results showed that SeNPs generated by Bacillus Subtilis SE201412 had a stable structure and a particle size of 126 ± 0.5 nm. It is easy for SeNPs with a particle size less than 200 nm to enter cells and complete a series of metabolic activities, and thus they exhibit higher biological activity38.
Figure 5.
Particle size of bioSeNPs in fermentation broth. (A) Particle size distribution of three replicates. (B) Average particle size distribution of three replicates. Error bars indicate ± 1 standard error of the mean. (C) Density of particle size of bioSeNPs.
We performed the toxicity tests of SeNP fermentation broth produced by strain SE201412 (Table 3). The results showed that all male and female mice died at 10,000 mg kg−1 and 4640 mg kg−1 doses. One male mouse died and 1 female animal died at 2150 mg kg−1 dose. No signs of poisoning or death were observed in males and females at the dose of 1000 mg kg−1 for 14 days. Gross autopsy results of all dead mice showed no pathological changes of poisoning. For male animals, LD50 (median lethal dose) was determined as 2710 mg kg−1, and for female animals, it was also 2710 mg kg−1. LD50 of chemically synthesized SeNPs and biosynthesized SeNPs has been reported to be 113.0 mg kg−1 and 198.1 mg kg-1, respectively, which was significantly lower than LD50 of selenate (1.6 mg kg−1), selenite (15.7 mg kg−1), and selenomethionine (27.0 mg kg−1)39. Our toxicity test of SeNPs fermentation broth produced by Bacillus Subtilis SE201412 showed an extremely low toxicity level with an LD50 value of 2710 mg kg−1, indicating that our prepared SeNPs fermentation broth was an extremely safe selenium supplementation resource with excellent application prospects.
Table 3.
Acute oral toxicity test result.
| Sex | Dose (mg kg−1) | Number | Body weight ( SD) (g) | Death number | Mortality (%) | |||
|---|---|---|---|---|---|---|---|---|
| Day 0 | Day 7 | Day 14 | Body weight gain in 14 days | |||||
| Male | 10,000 | 5 | 19.5 ± 1.18 | – | – | – | 5 | 100 |
| 4640 | 5 | 21.2 ± 0.68 | – | – | – | 5 | 100 | |
| 2150 | 5 | 20.0 ± 1.06 | 24.6 ± 0.80 | 29.6 ± 0.97 | 9.9 ± 1.33 | 1 | 20 | |
| 1000 | 5 | 20.4 ± 1.21 | 24.9 ± 0.89 | 29.6 ± 1.06 | 9.2 ± 1.61 | 0 | 0 | |
| Female | 10,000 | 5 | 20.4 ± 0.92 | – | – | – | 5 | 100 |
| 4640 | 5 | 20.6 ± 1.05 | – | – | – | 5 | 100 | |
| 2150 | 5 | 19.9 ± 0.95 | 24.6 ± 0.48 | 28.1 ± 0.46 | 7.9 ± 0.95 | 1 | 20 | |
| 1000 | 5 | 19.2 ± 0.47 | 23.9 ± 0.65 | 27.8 ± 1.03 | 8.6 ± 0.77 | 0 | 0 | |
Application of bio-nano-selenium fermentation broth in agriculture production
SeNPs can be used as soil selenium supplement in selenium-deficient areas, and they can be used as exogenous selenium for the cultivation of selenium-rich crops, thus improving the growth performance and oxidation resistance of crops. Selenium is involved in the physiological metabolism of crops, and it plays an important role in improving yield and quality, and enhancing the stress resistance of crops40. Many studies have been carried out on the biological activity and biosynthesis of SeNPs41. At present, SeNPs have been applied in multiple crops such as corn42, tomato43, radish44 and shepherd's purse45. However, most of the studies of selenium enrichment strategies in rice and wheat are based on inorganic selenium (selenite and selenate), and there are few reports on nano-selenium.
One previous study investigated the effect of selenite and selenate on the selenium content in grains of eight wheat varieties, and found the differences in selenium absorption of among different wheat varieties46. Another study conducted selenium biofortification by spraying selenate and selenite onto the wheat leaf surface, and found that both selenium sources significantly increased the selenium content in wheat grains, and after transformation, the proportion of organic selenium reached 72–93%47. In this study, BioSeNP fermentation broth at the same concentration and dosage was sprayed onto the leaves of 24 main wheat varieties in the middle and lower reaches of the Yangtze River in China. The results showed that there were differences in the absorption and utilization of the fermentation broth among 24 wheat varieties (Fig. 6), which was consistent with the previous reports46. However, one study has revealed that although there are differences in selenium absorption capacity among different wheat varieties, these differences were not statistically significant48. The possible reason might lie in that selenium absorption by wheat is also affected other factors such as environment temperature, soil selenium content, and application time of selenium supplement. In our study, the total selenium content in wheat grains ranged from 0.147–0.394 mg kg−1 with a mean value of 0.259 mg kg−1, and organic selenium content was 0.138–0.338 mg kg−1 with a mean value of 0.221 mg kg−1, accounting for 80–94.6% in total selenium with a mean percentage of 85.56%. Of 24 varieties, 19 wheat varieties exhibited a total selenium content greater than 0.2 mg kg−1, and their organic selenium percentage was above 80%. The percentage of organic selenium in wheat grains in our study was slightly higher that reported by Wang et al.46, which could be attributed to the smaller particle size of SeNPs in the fermentation broth, thus improving the absorption of organic selenium by wheat47.
Figure 6.

Total selenium content and organic selenium content in grains of 24 wheat varieties after foliar spraying of bioSeNP fermentation broth. (A) Xinmai 8811. (B) Ningmai 26. (C) Ermai 596. (D) Nannong 14Y106. (E) Wanximai 0638. (F) Ermai 251. (G) Eren 7. (H) Guohong 3. (I) Huamai 1168. (J) Huamai 2152. (K) Zhengmai 9023. (L) Ermai 170. (M) Xiangmai 35. (N) Xiangmai 55. (O) E Mai 23. (P) Hua mai 2668. (Q) Yang mai 20. (R) Xiang Mai 25. (S) E mai 18. (T) Yang mai 23. (U) E mai 580. (V) Hua Mai 2566. (W) E en 6. (X) E mai 352.
Likewise, different rice varieties have different selenium absorption, transport, and accumulation abilities49. Therefore, it is also important to select rice varieties with strong selenium enrichment ability in the actual production of selenium-rich rice. We selected two rice varieties E Xiang 2 and E Zhong 5 and applied the same concentration of BioSeNP fermentation broth at different dosages by foliar spraying to them, and compared the total and organic selenium contents in refined rice grains of the two varieties (Fig. 7). Our data showed that the total and organic selenium contents in the refined rice grains of the two varieties in selenium treatment groups were higher than those in control group (without selenium application). The percentage of organic selenium in the selenium treatment group of E Zhong 2 reached above 85%, and the total selenium content increased by 212.5–587.5%, and the organic selenium content increased by 368.7–968.7%, compared with that of CK. The total selenium content increased with the increase of selenium application amount. After foliar selenium spraying, the total selenium content in selenium treatment group of E Zhong 5 increased by 560% with the mean value of 0.33 mg kg−1, and the organic selenium content ranged from 0.142–0.419 mg kg−1, accounting for 88.91%, which was 1393% higher than that in CK group. The total and organic selenium contents in refined rice grains were directly proportional to the spraying dosage. Our results were consistent with previous report that exogenous selenium supplementation significantly increased the selenium content in rice grains50. Since selenium is mostly accumulated in the brown rice layer, the selenium content in refined rice is far lower than that in brown rice51. Therefore, low selenium content in refined rice is difficult to meet the daily selenium requirement by people who consume refined rice in their daily diet. The total selenium content and organic selenium percentage in rice applied with BioSeNP fermented from Bacillus subtilis SE201412 were significantly increased. Our results also indicated that rice exhibited a high bioavailable efficiency of SeNPs in fermentation broth.
Figure 7.
Total selenium content and organic selenium content in grains of two rice varieties under different selenium application doses. (A) Total selenium content and organic selenium content of E xiang 2. (B) Total selenium content and organic selenium content of E zhong 5.
Conclusion
This study investigated the ability of Bacillus subtilis SE201412 to convert sodium selenite into bio-nano-selenium. Our isolated and identified strain SE201412 could grow normally in the medium containing 66,000 mg L−1 (383 mM) sodium selenite, and its nano-selenium conversion rate exceeded 99% within 18 h. Additionally, fermentation broth with different selenium concentrations could be produced by this strain, and the average particle size of nano-selenium in fermentation broth was 126 nm. Toxicity test results showed that bioSeNP fermentation broth was safe with no side effects. The application of SeNP fermentation broth significantly increased the selenium content in wheat and rice grains and increased organic selenium percentage to above 80%. This study provides a new strategy for the application of bio-nano-selenium to different crops and varieties. Our developed bioSeNP fermentation broth based on Bacillus subtilis SE201412 exhibited great application prospects in agriculture. Our development and application of bioSeNP will contribute to meeting people's need for selenium supplementation.
Supplementary Information
Acknowledgements
The authors are grateful to Prof. Xi-Feng Ren (College of Plant Science and Technology, Huazhong Agricultural University, Wuhan, China) and Dr. Yu Zhou (College of Plant Science and Technology, Huazhong Agricultural University, Wuhan, China) for their help in the strain screening experiment. Thanks are also due to Dr. Ye Shen (Suzhou Institute of Nano-Tech and Nano-Bionics, Chinese Academy of Science, Suzhou, China) for her technical assistance with NTA.
Author contributions
Conceptualization, W.Z., H.L. and J.L.; methodology, S.H.; software, S.H.; validation, K.Y., S.H. and L.W.; formal analysis, S.H. and Q.L.; investigation, X.L. and J.S.; resources, W.Z.; data curation, H.L.; writing—original draft preparation, S.H.; writing—review and editing, K.Y.; visualization, S.H.; supervision, Z.Z.; project administration, W.Z. and H.L.; funding acquisition, W.Z. All authors have read and agreed to the published version of the manuscript.
Funding
Agricultural Technology Innovation Project of Hubei Province, China (2021-620-000-001-039).
Data availability
The datasets used and/or analysed during the current study are available from the corresponding author on reasonable request.
Competing interests
The authors declare no competing interests.
Footnotes
Publisher's note
Springer Nature remains neutral with regard to jurisdictional claims in published maps and institutional affiliations.
These authors contributed equally: Sisi Huang and Kan Yu.
Contributor Information
Wei Zheng, Email: fuxituandui@163.com.
Hongmei Luo, Email: 852911340@qq.com.
Jinlong Liu, Email: jlliu1618@163.com.
Supplementary Information
The online version contains supplementary material available at 10.1038/s41598-023-29737-z.
References
- 1.Zhang X, Hong R, Bei L, Yang J, Zhao X, Hu Z, Chen L, Meng H, Zhang Q, Niu G, Yue Y, Ke C. Selenium binding protein 1 inhibits tumor angiogenesis in colorectal cancers by blocking the Delta-like ligand 4/Notch1 signaling pathway. Transl. Oncol. 2022;18:101365. doi: 10.1016/j.tranon.2022.101365. [DOI] [PMC free article] [PubMed] [Google Scholar]
- 2.Bhattacharjee A, Basu A, Bhattacharya S. Selenium nanoparticles are less toxic than inorganic and organic selenium to mice in vivo. Nucleus. 2019;62:259–268. doi: 10.1007/s13237-019-00303-1. [DOI] [Google Scholar]
- 3.Hosnedlova B, Kepinska M, Skalickova S, Fernandez C, Ruttkay-Nedecky B, Peng Q, Baron M, Melcova M, Opatrilova R, Zidkova J, Bjorklund G, Sochor J, Kizek R. Nano-selenium and its nanomedicine applications: A critical review. Int. J. Nanomed. 2018;13:2107–2128. doi: 10.2147/IJN.S157541. [DOI] [PMC free article] [PubMed] [Google Scholar]
- 4.Li Y, Li X, Wong YS, Chen T, Zhang H, Liu C, Zheng W. The reversal of cisplatin-induced nephrotoxicity by selenium nanoparticles functionalized with 11-mercapto-1-undecanol by inhibition of ROS-mediated apoptosis. Biomaterials. 2011;32:9068–9076. doi: 10.1016/j.biomaterials.2011.08.001. [DOI] [PubMed] [Google Scholar]
- 5.Liu T, Zeng L, Jiang W, Fu Y, Zheng W, Chen T. Rational design of cancer targeted selenium nanoparticles to antagonize multidrug resistance in cancer cells. Nanomedicine. 2015;11:947–958. doi: 10.1016/j.nano.2015.01.009. [DOI] [PubMed] [Google Scholar]
- 6.Salem SS, Fouda A. Green synthesis of metallic nanoparticles and their prospective biotechnological applications: An overview. Biol. Trace Elem. Res. 2021;199:344–370. doi: 10.1007/s12011-020-02138-3. [DOI] [PubMed] [Google Scholar]
- 7.Visha P, Nanjappan K, Selvaraj P, Jayachandran S, Elango A, Kumaresan G. Biosynthesis and structural characteristics of selenium nanoparticles using Lactobacillus acidophilus bacteria by wet sterilization process. Int. J. Adv. Vet. Sci. Technol. 2015;4:178–183. doi: 10.23953/cloud.ijavst.183. [DOI] [Google Scholar]
- 8.Zhang C, Zhai X, Zhao G, Ren F, Leng X. Synthesis, characterization, and controlled release of selenium nanoparticles stabilized by chitosan of different molecular weights. Carbohydr. Polym. 2015;134:158–166. doi: 10.1016/j.carbpol.2015.07.065. [DOI] [PubMed] [Google Scholar]
- 9.Kumar A, Prasad KS. Role of nano-selenium in health and environment. J. Biotechnol. 2021;325:152–163. doi: 10.1016/j.jbiotec.2020.11.004. [DOI] [PubMed] [Google Scholar]
- 10.Song J, Zhou J, Li X, Li P, Tian G, Zhang C, Zhou D. Nano-selenium stablilized by Konjac Glucommannan and its biological activity in vitro. LWT. 2022;161:113289. doi: 10.1016/j.lwt.2022.113289. [DOI] [Google Scholar]
- 11.Zhang J, Ji T, Yang X, Liu G, Liang L, Liu X, Wen C, Ye Z, Wu M, Xu X. Properties of selenium nanoparticles stabilized by Lycium barbarum polysaccharide-protein conjugates obtained with subcritical water. Int. J. Biol. Macromol. 2022;205:672–681. doi: 10.1016/j.ijbiomac.2022.02.165. [DOI] [PubMed] [Google Scholar]
- 12.Yilmaz MT, İspirli H, Taylan O, Dertli E. A green nano-biosynthesis of selenium nanoparticles with Tarragon extract: Structural, thermal, and antimicrobial characterization. LWT. 2021;141:110969. doi: 10.1016/j.lwt.2021.110969. [DOI] [Google Scholar]
- 13.Pyrzynska K, Sentkowska A. Biosynthesis of selenium nanoparticles using plant extracts. J. Nanostruct. Chem. 2022 doi: 10.1007/s40097-021-00435-4. [DOI] [Google Scholar]
- 14.Afzal B, Yasin D, Naaz H, Sami N, Zaki A, Rizvi MA, Kumar R, Srivastava P, Fatma T. Biomedical potential of Anabaena variabilis NCCU-441 based Selenium nanoparticles and their comparison with commercial nanoparticles. Sci. Rep. 2021;11:13507. doi: 10.1038/s41598-021-91738-7. [DOI] [PMC free article] [PubMed] [Google Scholar]
- 15.El-Saadony MT, Saad AM, Taha TF, Najjar AA, Zabermawi NM, Nader MM, AbuQamar SF, El-Tarabily KA, Salama A. Selenium nanoparticles from Lactobacillus paracasei HM1 capable of antagonizing animal pathogenic fungi as a new source from human breast milk. Saudi J. Biol. Sci. 2021;28:6782–6794. doi: 10.1016/j.sjbs.2021.07.059. [DOI] [PMC free article] [PubMed] [Google Scholar]
- 16.Li K, Xu Q, Gao S, Zhang S, Ma Y, Zhao G, Guo Y. Highly stable selenium nanoparticles: Assembly and stabilization via flagellin FliC and porin OmpF in Rahnella aquatilis HX2. J. Hazard. 2021;414:125545. doi: 10.1016/j.jhazmat.2021.125545. [DOI] [PubMed] [Google Scholar]
- 17.Sun Y, Shi Y, Jia H, Ding H, Yue T, Yuan Y. Biosynthesis of selenium nanoparticles of Monascus purpureus and their inhibition to Alicyclobacillus acidoterrestris. Food Control. 2021;130:108366. doi: 10.1016/j.foodcont.2021.108366. [DOI] [Google Scholar]
- 18.Huang S, Wang Y, Tang C, Jia H, Wu L. Speeding up selenite bioremediation using the highly selenite-tolerant strain Providencia rettgeri HF16-A novel mechanism of selenite reduction based on proteomic analysis. J. Hazard. 2021;406:124690. doi: 10.1016/j.jhazmat.2020.124690. [DOI] [PubMed] [Google Scholar]
- 19.Tugarova AV, Mamchenkova PV, Khanadeev VA, Kamnev AA. Selenite reduction by the rhizobacterium Azospirillum brasilense, synthesis of extracellular selenium nanoparticles and their characterization. Nat. Biotechnol. 2020;58:17–24. doi: 10.1016/j.nbt.2020.02.003. [DOI] [PubMed] [Google Scholar]
- 20.Lian S, Diko CS, Yan Y, Li Z, Zhang H, Ma Q, Qu Y. Characterization of biogenic selenium nanoparticles derived from cell-free extracts of a novel yeast Magnusiomyces ingens. 3 Biotech. 2019;9:221. doi: 10.1007/s13205-019-1748-y. [DOI] [PMC free article] [PubMed] [Google Scholar]
- 21.Sara S, Mohammad M. Biosynthesis of selenium nanoparticles using Enterococcus faecalis and evaluation of their antibacterial activities. J. Trace Elem. Med. Biol. 2017;39:135–139. doi: 10.1016/j.jtemb.2016.09.003. [DOI] [PubMed] [Google Scholar]
- 22.Ministry of Land and Resources of the People's Republic of China. Analytic methods for biologic samples in eco-geochemistry assessment. Part 2: Determination of selenium content, fluorescent spectrophotometry, DZ/T0253.2-2014. Beijing, China (2014).
- 23.Al-Hagar O, Abol-Fotouh D, Abdelkhalek ES, Elsoud M, Sidkey NM. Bacillus niabensis OAB2: Outstanding bio-factory of selenium nanoparticles. Mater. Chem. Phys. 2021;273:125147. doi: 10.1016/j.matchemphys.2021.125147. [DOI] [Google Scholar]
- 24.Borah SN, Goswami L, Sen S, Sachan D, Narayan M. Selenite bioreduction and biosynthesis of selenium nanoparticles by Bacillus paramycoides SP3 isolated from coal mine overburden leachate. Environ. Pollut. 2021;285:117519. doi: 10.1016/j.envpol.2021.117519. [DOI] [PubMed] [Google Scholar]
- 25.Cremonini E, Zonaro E, Donini M, Lampis S, Boaretti M, Dusi S, Melotti P, Lieo MM. Biogenic selenium nanoparticles: Characterization, antimicrobial activity and effects on human dendritic cells and fibroblasts. Microb. Biotechnol. 2016 doi: 10.1111/1751-7915.12374. [DOI] [PMC free article] [PubMed] [Google Scholar]
- 26.Shakibaie M, Khorramizadeh MR, Faramarzi MA, Sabzevari O, Shahverdi AR. Biosynthesis and recovery of selenium nanoparticles and the effects on matrix metalloproteinase-2 expression. Biotechnol. Appl. Biochem. 2010;56:7–15. doi: 10.1042/BA2010.0042. [DOI] [PubMed] [Google Scholar]
- 27.Ashengroph M, Hosseini SR. A newly isolated Bacillus amyloliquefaciens SRB04 for the synthesis of selenium nanoparticles with potential antibacterial properties. Int. Microbiol. 2021;1:24. doi: 10.1007/s10123-020-00147-9. [DOI] [PubMed] [Google Scholar]
- 28.Jia, H. Molecular mechanism of reduction of selenite by Bacillus subtilis to synthesize nano-selenium. University of Science and Technology of China, PhD dissertation. 10.27517/d.cnki.gzkiu.2022.000947 (2022).
- 29.Yasir M, Zhang Y, Xu Z, Luo M, Wang G. NADPH-dependent thioredoxin-disulfide reductase TrxR is essential for tellurite and selenite reduction and resistance in Bacillus sp. Y3. FEMS Microbiol. Ecol. 2020;9:96. doi: 10.1093/femsec/fiaa126. [DOI] [PubMed] [Google Scholar]
- 30.Li BZ, Liu N, Li YQ, Jing W, Fan J, Li D, Zhang L, Zhang X, Zhang Z, Wang L. Reduction of selenite to red elemental selenium by Rhodopseudomonas palustris strain N. PLoS ONE. 2014;9:e95955. doi: 10.1371/journal.pone.0095955. [DOI] [PMC free article] [PubMed] [Google Scholar]
- 31.Tan YQ, Yao R, Wang R, Wang G, Zheng S. Reduction of selenite to Se (0) nanoparticles by filamentous bacterium Streptomyces sp. ES2-5 isolated from a selenium mining soil. Microb. Cell Fact. 2016;15:157. doi: 10.1186/s12934-016-0554-z. [DOI] [PMC free article] [PubMed] [Google Scholar]
- 32.Wang Y, Shu X, Hou JY, Lu W, Zhao W, Huang S, Wu L. Selenium nanoparticle synthesized by Proteus mirabilis YC801: An efficacious pathway for selenite biotransformation and detoxification. Int. J. Mol. Sci. 2018;19:3809. doi: 10.3390/ijms19123809. [DOI] [PMC free article] [PubMed] [Google Scholar]
- 33.Menon S, Agarwal H, Kumar SV, Rajeshkumar S. Biomemetic synthesis of selenium nanoparticles and its biomedical applications. In: Shukla AK, Iravani S, editors. Green Synthesis, Characterization and Applications of Nanoparticles. Elsevier; 2019. pp. 165–197. [Google Scholar]
- 34.Ghosh A, Mohod AM, Paknikar KM, Jain RK. Isolation and characterization of selenite-and selenate-tolerant microorganisms from selenium-contaminated sites. World J. Microbiol. Biotechnol. 2008;24:1607–1611. doi: 10.1007/s11274-007-9624-z. [DOI] [Google Scholar]
- 35.Neuhierl B, Thanbichler M, Lottspeich F, Bock A. A family of S-methylmethionine-dependent thiol/selenol methyltransferases: Role in selenium tolerance and evolutionary relation. J. Biol. Chem. 1999;274:5407–5414. doi: 10.1074/jbc.274.9.5407. [DOI] [PubMed] [Google Scholar]
- 36.Wang T, Yang L, Zhang B, Liu J. Extracellular biosynthesis and transformation of selenium nanoparticles and application in H2O2 biosensor. Colloids Surf. B. 2010;80:94–102. doi: 10.1016/j.colsurfb.2010.05.041. [DOI] [PubMed] [Google Scholar]
- 37.Dhanjal S, Cameotra SS. Aerobic biogenesis of selenium nanospheres by Bacillus cereus isolated from coalmine soil. Microb. Cell Fact. 2010;9:52. doi: 10.1186/1475-2859-9-52. [DOI] [PMC free article] [PubMed] [Google Scholar]
- 38.Peng D, Zhang J, Liu Q, Taylor EW. Size effect of elemental selenium nanoparticles (Nano-Se) at supranutritional levels on selenium accumulation and glutathione S-transferase activity. J. Biol. Inorg. Chem. 2007;101:1457–1463. doi: 10.1016/j.jinorgbio.2007.06.021. [DOI] [PubMed] [Google Scholar]
- 39.Shakibaie M, Shahverdi AR, Faramarzi MA, Hassanzadeh GR, Rahimi HR, Sabzevari O. Acute and subacute toxicity of novel biogenic selenium nanoparticles in mice. Pharm. Biol. 2013;51:58–63. doi: 10.3109/13880209.2012.710241. [DOI] [PubMed] [Google Scholar]
- 40.Salem SS, Fouda A. Green synthesis of metallic nanoparticles and their prospective biotechnological applications: An overview. Biol. Trace Elem. Res. 2020 doi: 10.1007/s12011-020-02138-3. [DOI] [PubMed] [Google Scholar]
- 41.Horky P. Uses of selenium nanoparticles in the plant production. Agron. J. 2021;11(11):2229. doi: 10.3390/agronomy11112229. [DOI] [Google Scholar]
- 42.Wang M, Wang Y, Ge C, Wu H, Jing F, Wu S, Li H, Zhou D. Foliar selenium nanoparticles application promotes the growth of maize (Zea mays L.) seedlings by regulating carbon, nitrogen and oxidative stress metabolism. Sci Hortic. 2022;311:111816. doi: 10.1016/j.scienta.2022.111816. [DOI] [Google Scholar]
- 43.Shiriaev A, Pezzarossa B, Rosellini I, Malorgio F, Lampis S, Ippolito A, Tonutti P. Efficacy and comparison of different strategies for selenium biofortification of tomatoes. Horticulturae. 2022;8(9):800. doi: 10.3390/horticulturae8090800. [DOI] [Google Scholar]
- 44.Huang S, Yu K, Xiao Q, Song B, Yuan W, Long X, Cai D, Xiong X, Zheng W. Effect of bio-nano-selenium on yield, nutritional quality and selenium content of radish. J. Food Compos. Anal. 2022;115:104927. doi: 10.1016/j.jfca.2022.104927. [DOI] [Google Scholar]
- 45.Wang C, Liu X, Chen F, Yue L, Cao X, Li J, Cheng B, Wang Z, Xing B. Selenium content and nutritional quality of Brassica chinensis L. enhanced by selenium engineered nanomaterials: The role of surface charge. Environ. Pollut. 2022;308:119582. doi: 10.1016/j.envpol.2022.119582. [DOI] [PubMed] [Google Scholar]
- 46.Wang M, Ali F, Qi M, Peng Q, Wang M, Banuelos GS, Miao S, Li Z, Dinh QT, Liang D. Insights into uptake, accumulation, and subcellular distribution of selenium among eight wheat (Triticum aestivum L.) cultivars supplied with selenite and selenate. Ecotoxicol. Environ. Saf. 2020;207:111544. doi: 10.1016/j.ecoenv.2020.111544. [DOI] [PubMed] [Google Scholar]
- 47.Wang M, Fayaz A, Wang M, Dinh QT, Zhou F, Banuelos GS, Liang D. Understanding boosting selenium accumulation in wheat (Triticum aestivum L.) following foliar selenium application at different stages, forms, and doses. Environ. Sci. Pollut. Res. 2020;27:717–728. doi: 10.1007/s11356-019-06914-0. [DOI] [PubMed] [Google Scholar]
- 48.Manojlovic M, Loncaric Z, Cabilovski R, Popovic B, Karalic K, Ivezic V, Ademi A, Singh B. Biofortification of wheat cultivars with selenium. Acta Agr. Scand. Sect. B Soil Plant Sci. 2019;69:715–724. doi: 10.1080/09064710.2019.1645204. [DOI] [Google Scholar]
- 49.Yi Q, Sun X, Tang S, Xu P, Pang Y, Huang X, Huang Q, Huang J, Zhang M. Comparation of Se accumulation and distribution of two rice (Oryza sativa L.) cultivars with high- and low-Se efficiency as affected by exogenous application of selenite. J. Cereal Sci. 2022;105:103475. doi: 10.1016/j.jcs.2022.103475. [DOI] [Google Scholar]
- 50.Gao M, Zhou J, Liu H, Zhang W, Hu Y, Liang J, Zhou J. Foliar spraying with silicon and selenium reduces cadmium uptake and mitigates cadmium toxicity in rice. Sci. Total Environ. 2018;631–632:1100–1108. doi: 10.1016/j.scitotenv.2018.03.047. [DOI] [PubMed] [Google Scholar]
- 51.De J, Pessoa M, Silva MJ, Ndayiragije A, Magaia HE, Cossa VSI, Reboredo FH, Carvalho ML, Santos JP, Guerra M. Simultaneous Zinc and selenium biofortification in rice accumulation, localization and implications on the overall mineral content of the flour. J. Cereal Sci. 2018;82:34–41. doi: 10.1016/j.jcs.2018.05.005. [DOI] [Google Scholar]
Associated Data
This section collects any data citations, data availability statements, or supplementary materials included in this article.
Supplementary Materials
Data Availability Statement
The datasets used and/or analysed during the current study are available from the corresponding author on reasonable request.